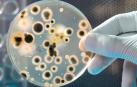
Escolares navarros, a la busca de nuevos antibióticos

BOLIVIA
La CIDH eleva a 23 los muertos y a 715 los heridos en la crisis de Bolivia
Estos datos actualizados se refieren a víctimas en choques entre cocaleros afines a Evo Morales y fuerzas del orden el pasado viernes

HONG KONG
Nuevos enfrentamientos entre manifestantes y Policía en Hong Kong
Las manifestaciones en Hong Kong comenzaron en junio a raíz de un polémico proyecto de ley de extradición, pero han mutado hasta convertirse en un movimiento que busca una mejora de los mecanismos democráticos de Hong Kong

El II Festival de Primera Infancia de Pamplona echa el telón esta semana
Todavía se puede participar en los talleres diseñados para experimentar en la instalación artística multisensorial de Condestable

'Thanks for the dance', la coda póstuma de un Leonard Cohen que amó la vida
El disco póstumo de Cohen saldrá a la luz el 22 de noviembre

Torra pide recuperar la figura del 'relator' para dialogar "sin condiciones"
Sobre las protestas que se han producido en Cataluña, celebra "que la ciudadanía se haya empoderado y haya salido a la calle masiva y pacíficamente"
Navarra consigue reducir un 9% el consumo de antibióticos
El Ministerio de Sanidad, Consumo y Bienestar Social ha lanzado la campaña “Los antibióticos NO valen para todo”

Guaidó convoca a la "protesta sostenida" en Venezuela, con Bolivia como ejemplo
El jefe del Parlamento hizo un nuevo llamamiento a los militares a levantarse contra Maduro

Una empresa de Pamplona, condenada por crear una web falsa de su competidora que remitía a una página porno
Los demandados tendrán que indemnizar con 3.000 euros a su competencia por daños y perjuicios

Ana Ollo reivindica en París la lucha de las hermanas Úriz Pi por la igualdad
Ha participado en la XXXIII Semana Cultural de Navarra en Paris organizada por la asociación Navarra Siempre

Comer por la noche, vinculado a una peor salud cardíaca para las mujeres
Las participantes del estudio informaban a diario de qué, cuánto y cuándo comieron durante una semana

EMPRESAS
El hotel Ciudad de Pamplona anuncia el cierre a sus empleados
Del grupo AC Hotels by Marriot y creado en 1978, cerrará el 20 de diciembre según ha trasladado a la plantilla

Estos son los cortes de tráfico de este domingo en Pamplona
El tráfico en el Casco Viejo puede verse afectado por la celebración de la Carrera del Teléfono de la Esperanza


